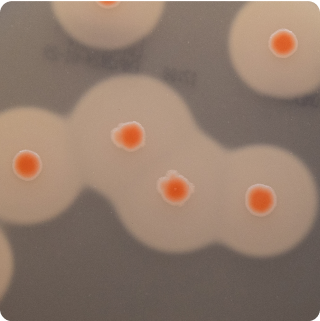

Bacillus Cereus - Plate - 50g
BACLS
|
Turnaround Time:
3 - 5 days

Method Description
Bacillus cereus is a spore-forming bacterium that causes two distinct types of food poisoning: emetic (vomiting) syndrome associated with rice dishes and diarrheal syndrome from various foods. Testing is important for foods that undergo cooking followed by holding at warm temperatures, as B. cereus spores survive cooking and can germinate during improper storage. The method uses selective media that distinguish B. cereus from other Bacillus species based on characteristic colony morphology and biochemical reactions.
Analyte List
Technical Data Sheet
Method Name
Enumeration of Presumptive Bacillus cereus
Method Code
LAB-TM-087
Equipment Type
Culture Media - Plate
Equipment Details
Bacara 2 Agar
Method Reference
Reportable Unit
CFU/g
Sample Size Requirements
Food Products: 100 grams
Dietary Supplements: 50 grams
Available for
Dietary Supplements, Food Products
Additional Information
Unavailable for
*Prices and offerings are subject to change without notice.